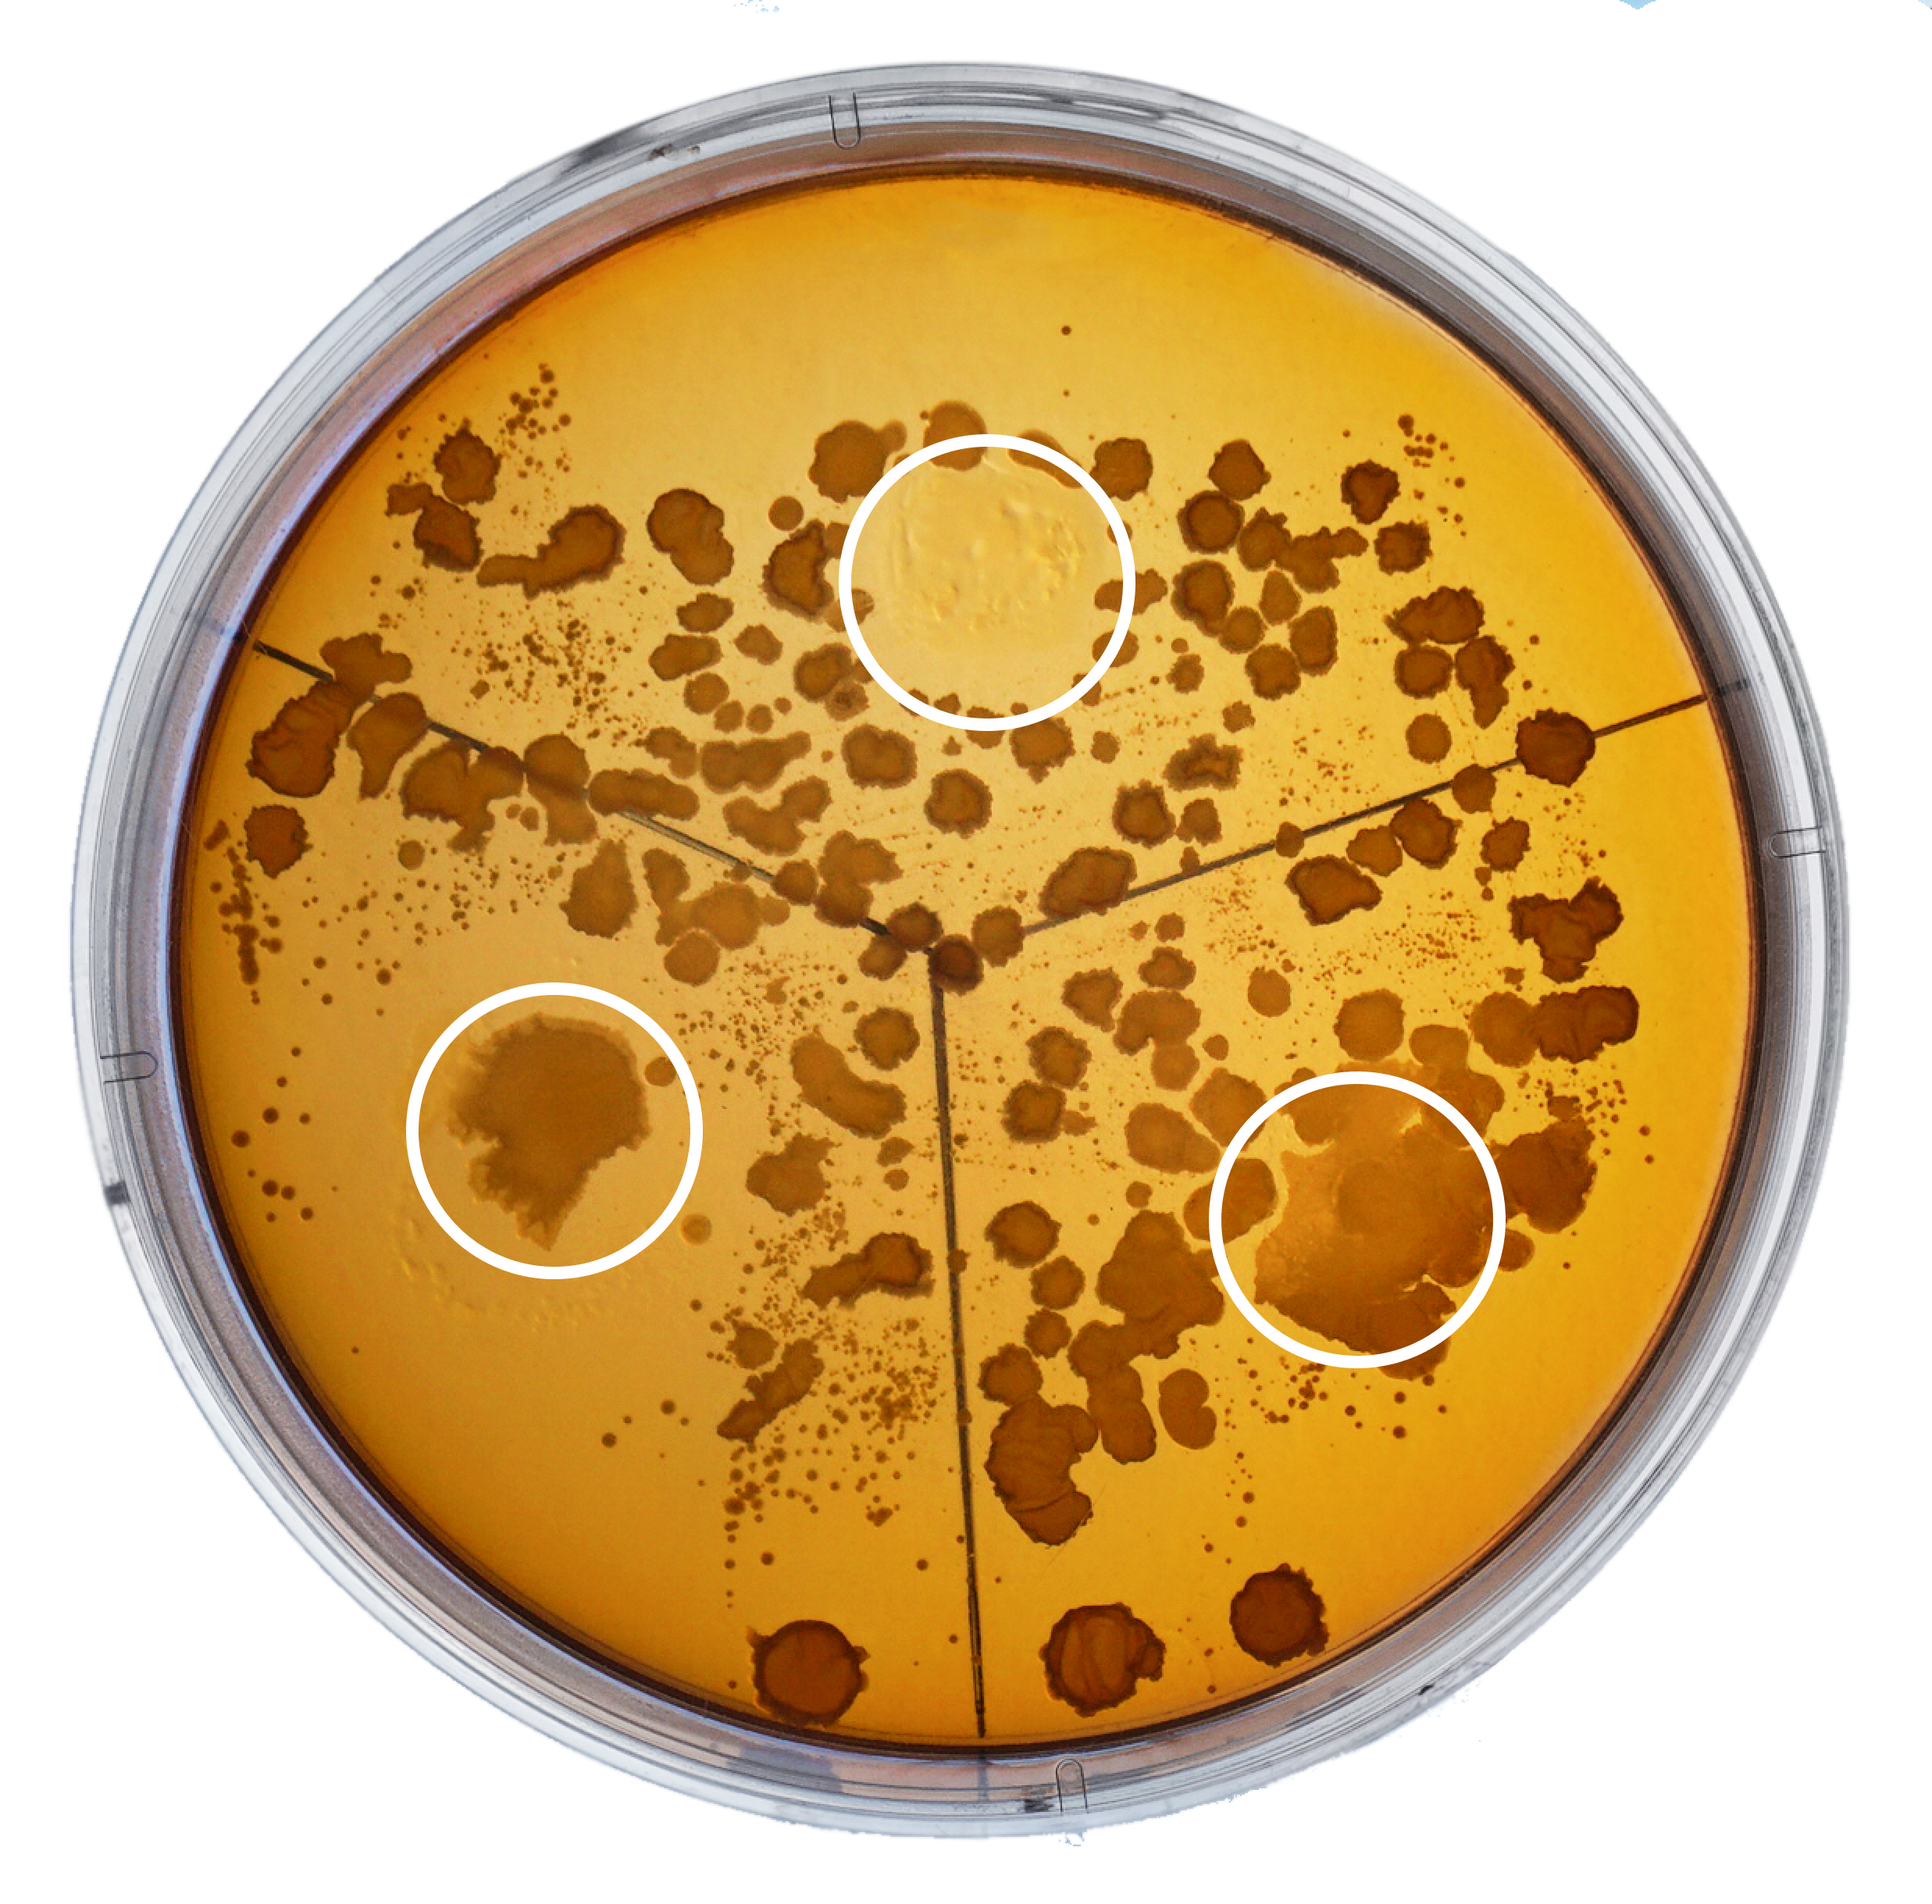

Можете выбрать удобный формат для сотрудничества
• Предоплата 100%
• Оплата 50/50
• Отсрочка платежа
• Открытый факторинг
• Доставка любой транспортной компанией
Оформите заявку, чтобы получить подробную консультацию
• Оплата 50/50
• Отсрочка платежа
• Открытый факторинг
• Доставка любой транспортной компанией
Оформите заявку, чтобы получить подробную консультацию
При нажатии на кнопку, Вы автоматически соглашаетесь на обработку персональных данных



Антибактериальный гель без спирта оптом от производителя
Сертифицированный гель с наночастицами серебра EVOLUT для безопасного очищения и обработки рук. Средство проверено дерматологами, учеными и обычными потребителями.




разрабатываем косметику с 2014 г.

Наши средства подходят для широкого спектра
Средство не содержит спирта, тем самым не будет сушить руки, пахнуть и раздражать сотрудников. К тому же EVOLUT дешевле спиртовых антисептиков.
Офисы, центры и студии
Малые и большие производства
Отели, гостиницы и салоны
Рестораны, кафе и бары



Преимущества антисептиков EVOLUT
БЕЗ СПИРТА
БЕЗ ЗАПАХА
БЕЗ ВРЕДНЫХ ВЕЩЕСТВ
АНТИБАКТЕРИАЛЬНО
БЕЗОПАСНО
НАДЁЖНО
Эффективен против грибков, бактерий и вирусов
Соответствует рекомендациям Роспотребнадзора и ВОЗ
Безболезненно и быстро
обеззараживает порезы и царапины
обеззараживает порезы и царапины
Бережно действует и не сушит кожу
Ускоряет заживление ран, снимает воспаление
Гель действует в течение 8 часов
Образует защитную пленку на коже
Подходит для взрослых и детей 3+








Средство прошло углубленные испытания на противовирусное и антибактериальное действие

Каталог антибактериальных средств
Можете выбрать любой товар из каталога
Наночастицы серебра обладают широким спектром противовирусного и противомикробного действия, низкой аллергенностью и токсичностью. Это делает их идеальным продуктом для использования в борьбе как с микробами, так и вирусами. Для нас важна эффективность веществ и их активное действие.

(цены указаны с НДС)
Фронтальный флакон 20 мл
от 66 ₽
• Классический
• С витамином Е
• С пантенолом
• С витамином Е
• С пантенолом

Канистра
3 л
3 л
от 790 ₽
• Классический

Флакон 50 мл
от 45 ₽
• Классический
• С витамином Е
• С пантенолом
• С витамином Е
• С пантенолом

Флакон 100 мл
от 50 ₽
• Классический
• С витамином Е
• С пантенолом
• С витамином Е
• С пантенолом

Флакон 300 мл
от 120 ₽
• Классический
• С витамином Е
• С пантенолом
• С витамином Е
• С пантенолом

Наносеребро - основной антибактериальный компонент


Отправьте нам сообщение и мы свяжемся с вами как можно быстрее
При нажатии на кнопку, Вы автоматически соглашаетесь на обработку персональных данных

Отправьте нам сообщение и мы свяжемся с вами как можно быстрее
При нажатии на кнопку, Вы автоматически соглашаетесь на обработку персональных данных
Сертификация и исследования геля EVOLUT
Сертификат соответствия выдан АНО «Наносертифика» на продукт «наночастицы серебра»
Протокол лабораторных и инструментальных испытаний для оценки антибактериальной эффективности геля «EVOLUT»
Оценка противовирусной активности и безопасности от ФБУН НИИДезинфектологии Роспотребнадзора
Патент на ранозаживляющий антибактериальный гель с пролонгированным действием
Свидетельство о государственной регистрации продукта «гель антибактериальный EVOLUT с наночастицами серебра»





Средство прошло сложные лабораторные испытания с увеличенными требованиями, в отличие от большинства продуктов косметического рынка, которые проходят по упрощенной системе сертификации с получением Декларации соответствия.
Гель с серебром EVOLUT имеет Свидетельство Государственной Регистрации (СГР)
vs
1-5 минут
До 8 часов
Не сушит кожу
Нет
30 секунд
Нет
Сушит кожу
Есть
EVOLUT
гель с изопропиловым спиртом
гель с этиловым спиртом
Скорость действия
Продолжительность действия
Воздействие на кожу
Запах
Наносеребро
Спирт
Скорость действия
Продолжительность действия
Воздействие на кожу
Запах
На фотографии наглядно видно, что участок с наносеребром не зарос бактериями, в отличии от участков со спиртами. Это связано с тем, что воздействие спирта на бактерии уменьшается после высыхания.

35₽ за 50мл
40₽ за 50мл
Стоимость
Стоимость
80% спиртовых санитайзеров на рынке - подделка. Многие производители используют технический (неочищенный) спирт, содержащий токсины и канцерогены. По результатам исследований EcoStandart group, большинство образцов не дали достаточного подавления роста высеянной флоры, а значит, не могут считаться эффективными антисептиками.

Наши преимущества
Уникальный товар
Весь наш товар сертифицирован. СГР, паспорт качества, протоколы испытаний, декларацию соответствия - предоставим по первому требованию.
Быстрая доставка
Сертификация
Основное преимущество нашего геля - его оригинальность и уникальность на рынке. Он всегда будет выделяться среди большого количества конкурентов.
Максимальный срок поставки до 2 недель. Мы проследим, чтобы ваш товар дошел к вам без проблем.
Оплата и доставка
Предоплата 100%
Оплата 50/50
Отсрочка платежа
Открытый факторинг
Доставка любой транспортной компанией
Оплата 50/50
Отсрочка платежа
Открытый факторинг
Доставка любой транспортной компанией

Нажмите на кнопку, чтобы получить подробную консультацию
Можете выбрать удобный формат для сотрудничества:

Отправьте нам сообщение и мы свяжемся с вами как можно быстрее
При нажатии на кнопку, Вы автоматически соглашаетесь на обработку персональных данных
Отзывы потребителей о продукте
Люблю санитайзеры от EVOLUT, они без спирта и не сушат руки.

Я выбрала среди всех антисептиков самый нормальный - Evolut - с наночастицами серебра

Знаю как они начинали, знаю как работают и ЧТО создают...знаю, что они невероятные молодцы!


Создаем антисептики с вашим логотипом
Специальное предложение для тех, кто хочет индивидуализировать косметику
Фронтальный флакон
1 000 шт. - 100 ₽
5 000 шт. - 80 ₽
10 000 шт. - 70 ₽
5 000 шт. - 80 ₽
10 000 шт. - 70 ₽

20

мл

Цены указаны с НДС
Цены указаны с НДС
Цилиндрический флакон
1 000 шт. - 65 ₽
5 000 шт. - 45 ₽
10 000 шт. - 37 ₽
5 000 шт. - 45 ₽
10 000 шт. - 37 ₽

100

мл
Цены указаны с НДС
Цилиндрический флакон
1 000 шт. - 60 ₽
5 000 шт. - 41 ₽
10 000 шт. - 33 ₽
5 000 шт. - 41 ₽
10 000 шт. - 33 ₽
50
мл


Отправьте нам сообщение и мы свяжемся с вами как можно быстрее
При нажатии на кнопку, Вы автоматически соглашаетесь на обработку персональных данных

Контакты
Компания ООО «М9 Фарм» - явлется производителем и разработчиком данной продукции. В наши услуги входят:
Контрактное производство косметики
Синтез наночастиц металлов
Разработка рецептур и технологий
Синтез наночастиц металлов
Разработка рецептур и технологий
чтобы получить полную консультацию по продуктам
+7 (927) 607 69 75
info@nmt-9.com


Напишите нам,




